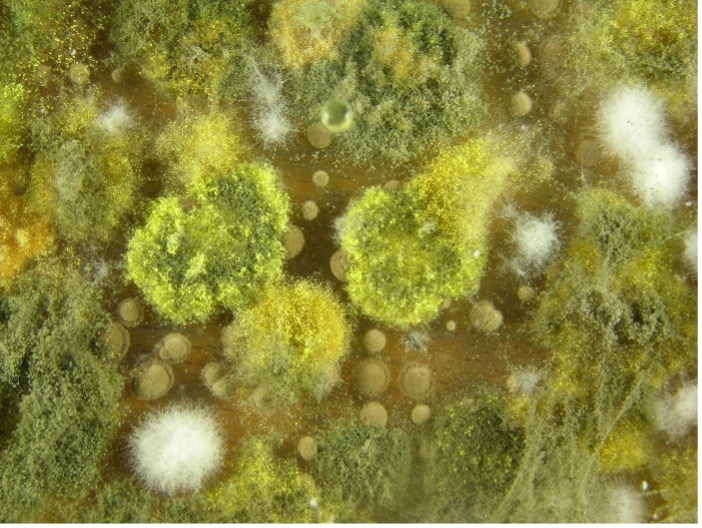

Mould spores in damp environments can trigger allergy and breathing symptoms. Learn how mould exposure affects health and how to reduce indoor mould allergens.
Mould is a common trigger for allergic rhinitis, often referred to as hay fever.
Allergic rhinitis is one of the most widespread allergic conditions in Australia, affecting around one in five people. Despite its name, it is not caused by hay and does not involve a fever.
Allergic rhinitis occurs when the lining of the nose and/or eyes comes into contact with allergens in the environment. These allergens may include pollen, dust mites, animal dander, and mould spores. Mould is found both indoors and outdoors, particularly in damp or poorly ventilated areas, and releases microscopic spores into the air that can be easily inhaled.
In people with allergies, the immune system mistakenly identifies these otherwise harmless substances as a threat. This immune response triggers the release of chemicals such as histamine, leading to inflammation and allergy symptoms. Common symptoms of allergic rhinitis include sneezing, a runny or blocked nose, itchy nose or throat, and watery or irritated eyes.
For individuals who are sensitive to mould, ongoing or repeated exposure can also lead to allergic conjunctivitis. This condition affects the eyes and may cause redness, itching, swelling, and excessive tearing. Symptoms may worsen in humid conditions or in environments where mould growth is present, such as bathrooms, basements, or water-damaged buildings.
Managing mould exposure, along with appropriate allergy treatment, can help reduce symptoms and improve quality of life for people with mould-related allergic rhinitis.
Instant access to allergy care
From quick online questionnaires to one-on-one consultations, we’re here to help you uncover triggers and find lasting relief.